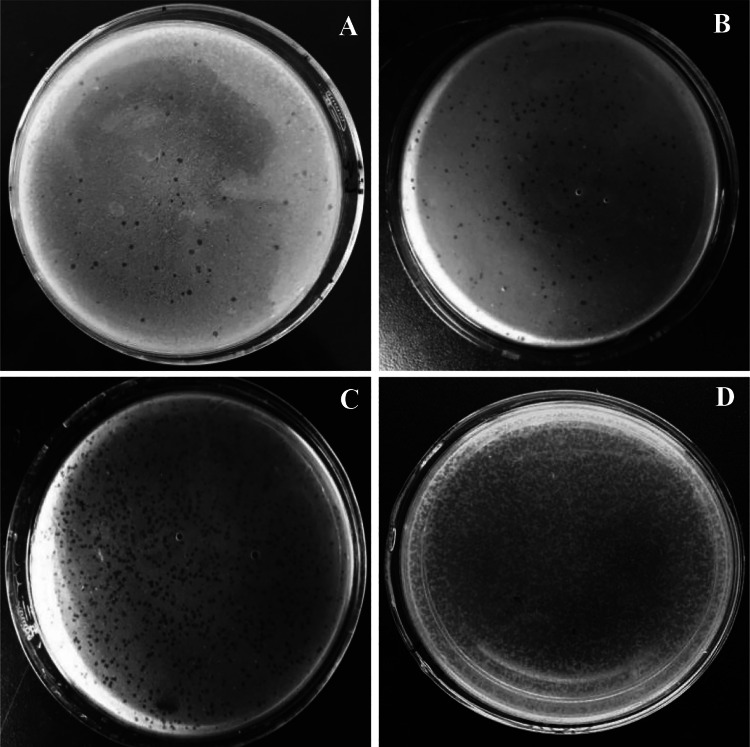
Fig. 2

Abstract
Halophilic phage are a type of virus that exist in salty environments within halophilic archaeal or bacterial hosts. However, relatively few reports on halophilic bacteriophages exist, and our overall understanding of halophilic bacteriophages is quite limited. We used SYBR Green I fluorescent staining to detect the abundance of viruses in Yuncheng Saline Lake, China. Using the double-layer plate method, a lytic phage that could infect halophilic bacterium Salinivibrio sp. YM-43 was isolated and named YXM43. We studied host range, optimal host, morphological characteristics, nucleic acid type, protein composition, and other biological characteristics of the virus. Results reveal a high abundance of this halophilic virus in Yuncheng Saline Lake. The newly isolated bacteriophage YXM43 has a narrow host range, with the most suitable host being Virgibacillus sp. SK39. After purification and enrichment, YXM43 is observed as a spherical particle with a diameter of approximately 30 nm, with no tail. No lipid envelope can be seen in YXM43. The capsid protein of the virus can be separated into seven proteins with molecular weights ranging from 62.0 to 13.0 kDa. YXM43 is a DNA virus with a genome approximately 23 kb. The virus is tolerant of low salinity, and its activity is highest at a temperature of 60 °C and a pH of 10. YXM43 is temperature and pH tolerant, and can adapt to environmental change, even withstanding chloroform treatment. The results indicate that bacteriophage YXM43 is a novel halophilic bacteriophage with broad tolerance to environmental change.
Keywords: Yuncheng Saline Lake, Halophile, Phage, Virgibacillus
Introduction
An substantial number of viruses exist in all three domains of life. Viruses play an active role in carbon and nutrient cycling in various environments, and in some extreme environments viruses play a significant role in host cell evolution [1]. Saline lakes are an extreme environment with high salt concentrations. Salt tolerant organisms such as halophilic archaea and bacteria have evolved to adapt to these high salt environments. Subsequently, a large number of halophilic viruses have co-evolved with halophilic archaea and bacteria in such environments [2, 3].
More than 100 halophilic phages have been isolated from high salt environments. Most of the host are halophilic archaea; just 10 viral strains have halophilic bacterial hosts [4]. Isolated halotolerant phages segregate into several morphological types: head-tailed contractile (Myoviridae), head-tailed noncontractile (Siphoviridae), head-tailed short (Podoviridae), pleomorphic (Pleolipoviridae), spherical (Sphaerolipoviridae), and spindle-shaped (Fuselloviridae) [5, 6].
Halophilic archaeal phages mostly belong to Caudoviruses which generally have linear double-stranded DNA (dsDNA) genomes, including head-tailed icosahedral halovirus HSTV-2 (Myoviridae), HVTV-1 (Siphoviridae), and HSTV-1 (Podoviridae) [7–9]. All are lytic phages, lacking genomic integrase sequences [7, 10]. The His1 virus is the only spindle-shaped halovirus isolated to date, despite this morphology being the most abundant in such environments [11, 12]. His2 was originally classified as spindle-shaped based on its morphological similarity to His1. However, His2 was later identified to have a different protein profile and reclassified to Pleolipoviridae [13, 14].
Much fewer halophilic bacterial phages have been isolated in high salt environments, with only a few over 10 strains thus far reported. Bacterial hosts belong to several genera, including Halomonas, Pseudomonas, Salinivibrio, Salicola, Salisaeta, Virgibacillus, and Chromohalobacter [15–21]. Most of the isolated halophilic bacteriophages are Siphoviridae or Myoviridae types, but Podoviridae and Sphaerolipoviridae phage have also been isolated. Calvo used strain Halomonas halophila F9-11 to screen phage F9-11 after mitomage C treatment [15]. F9-11 has an equal head to non-contractile tail ratio, and either too high or too low of a salt concentration affects viral adsorption. Kukkaro et al. isolated the phage SCTP-1 that infects Salicola sp. PV3, and its adsorption rate increases with increasing salinity [22]. A lytic halophage QHHSV-1 was isolated from the Qiaohou Salt Mine in Yunnan Province in China with Halomonas ventosae QH 52–2 as the host [23]. QHHSV-1 is stable throughout a wide thermal range. The acceptable host infection salinity range is 2.0–20% (optimal salinity 5%), yet it can maintain stability for long times under 0–30% salt concentration [23]. Myoviridae SCTP-2, the largest known halophage infecting prokaryotes, has a head diameter of approximately 125 nm, and a contractile tail of approximately 145 nm. Similar to SCTP-1, SCTP-2 has extensive salt tolerance [24]. We found several halophages in Yuncheng Saline Lake and Salin Lake, China, in past research. Two representatives follow. Podoviridae CJL-1 has a head diameter of 110 nm and a tail length of 25 nm [25]. CJL-1 has a lipid envelope, and a wide host range, including halophilic bacteria Clostridium sp. GQ5 and Halomonas sp. GQ62. JMT-1 is a spherical virus. Its host is Chromohalobacter sp. LY7-3 isolated from Salin Lake [26]. JMT-1 can infect at least five different halophilic bacteria. Halophages such as CJL-1 and JMT-1 that can infect multiple hosts are quite rare.
Materials and Methods
Virus Enumeration
Virus enumeration was followed Suttle CA and Fuhrman JA’s method [27]. We sampled 15 mL aliquots of Yuncheng Saline Lake water, adding 3 μL of DNase I and 1.5 μL of RNase A to each, and then incubated the samples for 30 min. Samples were then filtered with a 0.22 μm cellulose acetate filter to remove large cell particles. 250 μL of SYBR Green I (SY1020, Solarbio, Beijing, China) was added to 10 mL of the filtrate and stored in the dark for 15 min. After filtering with a 0.02 μm Anopore alumina filter membrane, 1 mL of anti-fading agent (50% glycerol, 50% PBS, 0.1% p-phenylenediamine, stored away from light) was added. The treated filter membrane was then gently placed on a glass slide and virus like particles (VLP) were counted under a fluorescence microscope (TS100, Nikon, Tokyo, Japan). The number of VLP per ml of Saline Lake water was calculated as follows: VLP/mL = NX/V. Here, N is membrane area/field area, X is the average number of viruses counted per field, V is the volume of water filtered (10 mL).
Bacterial Strains
The halophilic strains used to detect the host range in this study were isolated from Yuncheng Saline Lake, China. 16S rRNA gene accession numbers of the strains were obtained from NCBI Genbank.
Culture Media
Media was prepared as described on an online website (https://haloarchaea.com/halohandbook/) for cultivating halophilic bacteria. Artificial salt water (SW) contained 4 M NaCl, 150 mM MgCl, 150 mM MgSO4, 90 mM KCl, and 3.5 mM CaCl2 (a total of 30% (w/v) salt) and adjusted to pH 7.5. For use as a virus dilution solution (VDS), the SW was diluted to half as 50% SW, with a total of 15% (w/v) salt. Overlay plates of modified growth medium (MGM) contained 15 mM Tris–HCl (pH 7.5), 1% yeast extract, 0.5% peptone, and 15% total SW. Agar was added for the solid (15 g/L) or top-layer (5 g/L) media. Luria–Bertani (LB) medium contained 1% tryptone, 0.5% yeast extract, and 0.5% NaCl, adjusted to pH 7.5.
Isolation of Bacteriophage YXM43
Water from Yuncheng Saline Lake and LB medium were mixed 2:1 and cultured at 37 °C on a shaker for 24 h. The mixture was centrifuged at 8000 rpm for 30 min. After that, the precipitate was resuspended in 0.5 mL VDS. The suspension was filtered using a 0.22 μm microporous membrane and stored at 4 °C.
A suspension of 150 μL of the filtrate and 50 μL Salinivibrio sp. YM-43 (16S rRNA Accession Number: KX099325.1) was then incubated at room temperature (RT) for 15 min. Next, the mixture was blended with 3 mL of top-layer 15% MGM and spread on solid MGM. This mixture was cultured at 37 °C for 24 h. Two plaques on a Salinivibrio sp. YM-43 lawn plate were obtained and resuspended in 100 μL VDS. The resuspended VDS was stored as a storage solution. To test the infective ability of the novel virus, 10 μL storage solution was added on the 4 mL top-layer MGM with 100 μL Salinivibrio sp. YM-43 and cultured for 24 h at 37 °C. The virus from just one plaque could infect the test halobacterial strain. The novel virus was named YXM43.
Host Range Test of YXM43
We used 20 halophilic bacterium strains to test the halophage YXM43 host range. All strains were isolated from Yuncheng Saline Lake (China) (16S rRNA Genbank accession numbers are listed in Table 1). The strains were used to screen for YXM43 susceptibility. The lysates from YXM43-infected halophilic bacterium cultures were spotted onto the lawns of each strain (using media with 18% MGM) and incubated for 72 h at 37 °C. The most suitable phage host was Virgibacillus sp. SK39 (see below) and it was selected for subsequent experiments.
Table 1.
The bacteria used for host range test
| Strain | 16S rRNA Gene access number | Strain | 16S rRNA Gene access number |
|---|---|---|---|
| Clostridiaceae GQ5 | JQ421339.1 | Halomonas sp. GQ41 | JQ028723.1 |
| Clostridiaceae GQ8 | JQ421332.1 | Halomonas sp. GQ44 | JQ421337.1 |
| Clostridiaceae GQ13 | JQ421320.1 | Halomonas sp. GQ51 | JQ028724.1 |
| Clostridium sp. GQ15 | JQ421317.1 | Halomonas sp. SK6 | JN998407.1 |
| Clostridiaceae GQ18 | JQ421334.1 | Idiomarina sp. W33 | JN112009.1 |
| Chromohalobacter sp. LY7-3 | HQ683729.1 | Salimicrobium sp. LY19 | HQ683737.1 |
| Chromohalobacter sp. LY15 | HQ683735.1 | Salinivibrio sp. YM-43 | KX099325.1 |
| Gracilibacillus sp. SK1 | JQ045293.1 | Thalassobacillus sp. LY18 | HQ683736.1 |
| Halobacillus sp. LY6 | HQ683725.1 | Virgibacillus sp. GQ3 | JQ421338.1 |
| Halobacillus sp. LY7 | HQ683726.1 | Virgibacillus sp. SK39 | JN998440.1 |
Purification of Bacteriophage YXM43
The most suitable host, Virgibacillus sp. SK39, was infected with bacteriophage YXM43 on double-plate MGM, and phage stocks were produced. The top-layer MGM was collected with 4 mL VDS. The cultures in VDS were blended on a vortex for 2 min and then centrifuged at 10,000 rpm for 3 min. To purify YXM43, the supernatant was collected and filtered via a 0.22 μm microporous membrane. After collection, YXM43 was precipitated with 10% (w/v) polyethylene glycol for 12 h at 4 °C and then centrifuged at 12,000 rpm for 15 min. The precipitate was dissolved in 1 mL VDS. These steps were repeated four times until more than 90% lysis of Virgibacillus sp. SK39 was observed. The purified bacteriophage YXM43 was collected in 1 mL VDS.
Transmission Electron Microscopy of Phage YXM43
YXM43 was imaged using a Philips CM 120 BioTwin transmission electron microscope (TEM) (Royal Philips Electronics, Amsterdam, Netherlands), which was operated at 120 kV acceleration voltage. 10 µL of phage suspension was adsorbed to a 300 mesh Formvar copper film grid for 1 min. The grid was rinsed with sterile water for 15 s and stained with 0.2% w/v uranyl acetate for 2 min, air dried, and then imaged [26].
Capsid Protein Analysis of YXM43
YXM43 was precipitated and resuspended in double distilled H2O (ddH2O). Then 35 µL of the YXM43 resuspension was added to 15 µL Laemmli sample buffer (Bio-Rad, California, USA) and 48 mM β-mercaptoethanol, mixed, and heated in boiling water for 5 min. After that, the sample was separated by 12% sodium dodecyl sulfate polyacrylamide gel electrophoresis (SDS-PAGE). The gels were stained for 30 min with Coomassie Brilliant Blue buffer (CBB) (0.25% Coomassie Brilliant Blue, 5% methanol, 7.5% acetic acid) and then destained with 40% methanol and 10% acetic acid several times until the protein bands were clearly revealed.
Nucleic Acids Analysis of YXM43
Nucleic acids isolation was performed based on the methods of Porter et al. [28]. Purified halophage YXM43 nucleic acids were prepared to identify nucleic acid type after protease treatment. RNase A (5 U/μg) and DNase I (20 U/μg) were added separately for 1 h at 37 °C. Total nucleic acids, and the Rnase A and DNase I treated nucleic acid samples were checked on 1% agarose gels. After staining with ethidium bromide, the products were photographed under UV light.
Stability of YXM43
The bacteriophages were collected in VDS, and virus titers were determined by plaque assay on Virgibacillus sp. SK39. The effect of a low-ionic environment was tested through the dilution of YXM43 (in MGM) with ddH2O (1:1000, phage to ddH2O), the incubation was performed every 5 min (from 0 to 30 min), and the mixture was quickly cultured in MGM for 12 h to detect the titer. YXM43 thermal stability was tested after every 30 min, at 60, 70, and 80 °C, then the phages were quickly incubated at 4 °C, diluted in VDS, and cultured with Virgibacillus sp. SK39 in MGM for 12 h to determine titer. The YXM43 pH stability test was determined via dilution of YXM43 in MGM into appropriate pH VDS. VDS pH was adjusted from 4 to 10 using Tris–HCl. After 30 min, 20 µL YXM43 and 50 µL Virgibacillus sp. SK39 were cultured in MGM for 12 h to detect titer. Chloroform sensitivity was examined through exposure of YXM43 in MGM to chloroform in a volume ratio of 5:1 (phage to chloroform). The incubation was performed every 5 min (from 0 to 30 min), and then 10 µL supernatant and 50 µL Virgibacillus sp. SK39 were blended at RT for 15 min, and the mixture was cultured on MGM for 12 h to determine titer.
Results
Virus from Yuncheng Saline Lake Enumeration by Fluorescence Microscopy with SYBR Green I
The VLP is green under fluorescence microscopy, and those virus particles stained by SYBR Green I are easily distinguished from the background (Fig. 1). The virus content in the water samples collected is relatively abundant, nearly 2.95 × 106 VLP/mL.
Fig. 1.

Virus enumeration by epifluorescence microscopy. The green points represent virus particles (color figure online)
Bacteriophage Isolation and Host Range Test
At collection time, Yuncheng Saline Lake (China) had a total salinity of 30%, pH of 7.2, and temperature of 19.8 °C. Water samples from Yuncheng Saline Lake were used to screen for halovirus via direct plating on lawns of Salinivibrio sp. YM-43 using MGM with 15% salt. Just two plaques were observed on the plates, and only one could be isolated. The novel halovirus was named YXM43.
Twenty halobacterial stains were used to test host range. After culturing for 2 days at 37 °C, YXM43 was unable to form plaques on the lawns of most species except Salinivibrio sp. YM-43 and Virgibacillus sp. SK39. Many more plaques occurred on Virgibacillus sp. SK39 than on Salinivibrio sp. YM-43, meaning Virgibacillus sp. SK39 is a better YXM43 host. These findings indicate that the novel bacteriophage has a quite narrow host range.
After Virgibacillus sp. SK39 was determined to be an optimal host bacterium, it was used to propagate sufficient purified YXM43 for further analyses. Virgibacillus sp. SK39 was infected with bacteriophage YXM43 on double-plate MGM, and phage stocks were produced (Fig. 2a). The clear plaques were 1–3 mm in diameter, and the edges were smooth on MGM. The plaques were collected with Virgibacillus sp. SK39 and such operations were performed three more times. Plaque incidence increased over the course of the replications, and a high titer of similar plaque morphology was observed on the plates (Fig. 2b–d).
Fig. 2.
The bacteriophage YXM43 on MGM. Virgibacillus sp. SK39 was used as the host bacteria, the plaques were distributed evenly on MGM. a–d means the situation after multiple screenings for phage purification
TEM of YXM43
The negative-stain electron microscopy images show YXM43 as a spherical particle, with a diameter of approximately 30 nm (Fig. 3a). The images also suggest that YXM43 has no tail, and no distinct outer lipid layer can be discerned (Fig. 3b).
Fig. 3.
Purified YXM43 virus particles examined by negative-stain electron microscopy. Scale bar represents 50 nm. a TEM image of YXM43; b Enlarged view of the red box in A (color figure online)
Capsid Protein Analysis and Genome Characteristics of YXM43
The YXM43 protein profile was determined using SDS-PAGE. Seven primary structural proteins (SP1–SP7) could be detected in YXM43. The molecular weights were 62.0 KDa, 57.0 KDa, 50.0 KDa, 45.0 KDa, 37.0 KDa, 26.0 KDa, and 13.0 KDa, respectively (Fig. 4).
Fig. 4.

Capsid proteins of YXM43. Viral structural proteins were separated by SDS-PAGE. SP1-SP7, structural protein 1–7. The molecular weight were 62.0 KDa, 57.0 KDa, 50.0 KDa, 45.0 KDa, 37.0 KDa, 26.0 KDa, 13.0 KDa respectively
The YXM43 genome is approximately 23 kb long (Fig. 5). Nucleic acids extracted from YXM43 were treated with RNase A or DNase I. Agarose gel images show that the genome is sensitive to DNase I but cannot be digested by RNase A (Fig. 5). These results indicate that the YXM43 is a DNA virus.
Fig. 5.

Nucleic acid typing for YXM43. M, λ DNA Hind III marker; YXM43, the length of YXM43 genome; RNase A, YXM43 nucleic acid treated with RNase A; DNase I, YXM43 nucleic acid treated with DNase I
Stability Tests of YXM43
Salinity, temperature, and pH significantly affect YXM43. YXM43 consistently grows in salinities anywhere between 0 and 30% total salts. The phage could grows at 25% salinity, with phages titers up to 3.8 × 106 PFU/mL. However, growth at 30% salinity is optimal, with titers up to 4.3 × 106 PFU/mL (Fig. 6a). These findings confirm that YXM43, like other Virgibacillus-host phage, is a halophilic species.
Fig. 6.
Stability of YXM43 to various treatments and conditions. a the effect of lowered salt concentration on YXM43; b the effect of various temperatures (30–80 °C) on YXM43; c the effect of various pH (4–10) on YXM43; d the effect of chloroform on YXM43. The titer was detected after treatment
A broad tolerance was also observed in the thermal stability experiment. The phage was stable from 30 to 70 °C. The titer was highest when the temperature was raised to 60 °C (5.8 × 106 PFU/mL). However, when the temperature reached 80 °C, the phage could not reproduce. Compared with the titer at 60 °C, the survival rates of YXM43 at 30, 40, 50 and 70 °C were 48.3%, 53.4%, 63.8%, and 62.1%, respectively. This finding suggests that YXM43 has a high stability in different temperature environments (Fig. 6b).
Like temperature stability, YXM43 has a broad pH tolerance. The YXM43 phage was tolerant of both acidic and basic conditions—no difference in infectivity was observed between pH 4–9. A significantly increased overall pH effect did occur at pH 9–10: The titer went from approximately 1.3 × 106 PFU/mL up to 2.9 × 106 PFU/mL during the course of the experiment (Fig. 6c).
Chloroform treatment significantly affects the activity of the phage YXM43. As shown in Fig. 6d, YXM43 titer decreases sharply with an increase in chloroform processing time, indicating the presence of lipids in the viral capsid or a surrounding lipid layer, even though it is not seen under TEM.
Discussion
YXM43 is a novel lytic halophilic virus that infects bacteria in Yuncheng Saline Lake, an environment where the salt concentration can reach saturation. YXM43 is a DNA virus that can adapt to changing environments and has a high tolerance for temperature, salt concentration, and pH changes. Strains Salinivibrio sp. YM-43 and Virgibacillus sp. SK39 from Yuncheng Saline Lake are YXM43’s natural hosts, with Virgibacillus sp. SK39 being far more suitable.
Many halophilic archaeal viruses have been reported, but halophilic bacterial phages are rare in the literature. Moreover, if plaque formation is used to assay infection, persistent or temperate infection is difficult to assess, and, therefore, difficult to interpret host-range. Most haloarchaeoviruses have been reported to have a narrow host range, and this has been attributed to a small receptor range of virus attachment proteins rather than to DNA restriction barriers [24]. For halophilic bacteriophages, this situation may also exist. Additionally, in similar salty lake environments, different bacteriophages behave differently. For example, SH1 [25] and PH1 [28] are phages isolated from Australian salt lakes, living in environments similar to YXM43’s. However, both SH1 and PH1 are more sensitive to low-salt environments versus YXM43, which is more adaptable to these environments.
Compared with four other reported halophilic viruses, YXM43 has both commonality and uniqueness. Phage YXM43, JMT-1 [26], and SCTP-1 [29] are tolerant to changes in salinity, being adapted to survival in both lower and higher salt concentration environments. At the same time, the pH adaptability of YXM43 and viruses CJL-1 [30] and JMT-1 is significant, all three being able to survive both acidic and alkaline environments. The phage Mimir87’s [31] host is also in the genus Virgibacillus, but little information exists about the physiological and biochemical properties of Mimir87. YXM43 also has more thermal stability compared with the first three. It can survive at 70 °C and has an optimal growth temperature of 60 °C (Table 2). This may relate to the saline lake environment where the virus lives. However, this saline lake environment is not static. Its salt concentration, pH, and temperature change dynamically. The virus has long co-evolved with its hosts to adapt to these unstable conditions to survive.
Table 2.
Physicochemical responses of YXM43 and other described bacterial halophilic viruses
| Virus | YXM43 | Mimir87 | CJL-1 | JMT-1 | SCTP-1 |
|---|---|---|---|---|---|
| Source | Saline lake (China) | Worker honey bees | Saline lake (China) | Saline lake (China) | Saltern (Italy) |
| Host | Virgibacillus sp. SK39 | Virgibacillus halotolerans | Virgibacillus sp. GQ15 | Chromohalobacter sp. LY7-3 | Salicola sp. PV3 |
| Salinity (%) | |||||
| Tolerance range | Survived after being diluted 1000 times | NR | NR | Survived after being diluted 1000 times | 0–26 |
| Maximum exposure time | > 30 min | NR | NR | > 35 min | 15 min |
| pH | |||||
| Tolerance range | 4–10 | NR | 5–9 | 4–10 | NR |
| Optimum pH | 10 | NR | 7 | 7 | NR |
| Temperature (°C) | |||||
| Maximum temperature tolerated | 70 | NR | 50 | 30–70 | NR |
| Optimum temperature | 60 | NR | 40 | 40 | NR |
Acknowledgements
This work was supported by Science and Technology Innovation Project of Higher Education Institutions in Shanxi Province (2019L0859); Discipline project of “Characteristic Agricultural Products Development” (XK-2019012); Key discipline construction of Yuncheng University; Shanxi Basic Research Program (Free Exploration) (20210302123080). We also thank Steven M. Thompson from Liwen Bianji (Edanz) (www.liwenbianji.cn/), for editing the English text of a draft of this manuscript.
Declarations
Conflict of interest
The authors declare that they have no conflict of interest.
Human or Animals Participants
This article does not contain any studies with human participants or animals performed by any of the authors.
Footnotes
Publisher's Note
Springer Nature remains neutral with regard to jurisdictional claims in published maps and institutional affiliations.
References
- 1.Forest R, Rebecca VT. Viruses manipulate the marine environment. Nature. 2009;459:207–212. doi: 10.1038/nature08060. [DOI] [PubMed] [Google Scholar]
- 2.Priya N, Sheila P, Juan AU, et al. De novo metagenomic assembly reveals abundant novel major lineage of Archaea in hypersaline microbial communities. ISME J. 2012;6:81–93. doi: 10.1038/ismej.2011.78. [DOI] [PMC free article] [PubMed] [Google Scholar]
- 3.Francisco RV, Ana B, Martin C, et al. Explaining microbial population genomics through phage predation. Nat Rev Microbiol. 2009;7:828–836. doi: 10.1038/nrmicro2235. [DOI] [PubMed] [Google Scholar]
- 4.Atanasova NS, Oksanen HM, Bamford DH. Haloviruses of archaea, bacteria, and eukaryotes. Curr Opin Microbiol. 2015;25:40–48. doi: 10.1016/j.mib.2015.04.001. [DOI] [PubMed] [Google Scholar]
- 5.Alison L, Timothy W, Susanne E, et al. Viruses of Haloarchaea. Life. 2014;4:681–715. doi: 10.3390/life4040681. [DOI] [PMC free article] [PubMed] [Google Scholar]
- 6.Pietilä MK, Atanasova NS, Manole V, et al. Virion architecture unifies globally distributed pleolipoviruses infecting halophilic archaea. J Virol. 2012;86:5067–5079. doi: 10.1128/JVI.06915-11. [DOI] [PMC free article] [PubMed] [Google Scholar]
- 7.Pietilä MK, Laurinmäki P, Russell DA, et al. Insights into head-tailed viruses infecting extremely halophilic archaea. J Virol. 2013;87:3248–3260. doi: 10.1128/JVI.03397-12. [DOI] [PMC free article] [PubMed] [Google Scholar]
- 8.Ana S, Elina R. A Glimpse of the genomic diversity of haloarchaeal tailed viruses. Front Microbiol. 2014;5:84–89. doi: 10.3389/fmicb.2014.00084. [DOI] [PMC free article] [PubMed] [Google Scholar]
- 9.Ackermann HW, Prangishvili D. Prokaryote viruses studied by electron microscopy. Arch Virol. 2012;157:1843–1849. doi: 10.1007/s00705-012-1383-y. [DOI] [PubMed] [Google Scholar]
- 10.Ana S, Deborah JS, Daniel AR, et al. Snapshot of haloarchaeal tailed virus genomes. RNA Biol. 2013;10:803–816. doi: 10.4161/rna.24045. [DOI] [PMC free article] [PubMed] [Google Scholar]
- 11.Aharon O, Mikal H, Svein N, et al. Intracellular ion and organic solute concentrations of the extremely halophilic bacterium Salinibacter ruber. Extremophiles. 2002;6:491–498. doi: 10.1007/s00792-002-0286-3. [DOI] [PubMed] [Google Scholar]
- 12.Oren A, Ventosa A. International committee on systematics of prokaryotes; subcommittee on the taxonomy of Halobacteriaceae. Int J Syst Evol Microbiol. 2014;64:3914. doi: 10.1099/ijs.0.069922-0. [DOI] [PubMed] [Google Scholar]
- 13.Francisco RV, Ana-Belen MC, Beltran RB, et al. Explaining microbial population genomics through phage predation. Nat Rev Microbiol. 2009;7:828–836. doi: 10.1038/nrmicro2235. [DOI] [PubMed] [Google Scholar]
- 14.Curtis AS. Marine viruses-major players in the global ecosystem. Nat Rev Microbiol. 2007;5:801–812. doi: 10.1038/nrmicro1750. [DOI] [PubMed] [Google Scholar]
- 15.Concepción C, Ana GP, Victoria B, et al. Isolation and characterization of phage F9–11 from a lysogenic Deleya halophila strain. Curr Microbiol. 1988;17:49–53. doi: 10.1007/BF01568819. [DOI] [Google Scholar]
- 16.Conceptión C, Ana GP, Fernando MC, et al. Behaviour of two D. halophila bacteriophages with respect to salt concentrations and other environmental factors. Toxicol Environ Chem. 1994;43:85–93. doi: 10.1080/02772249409358020. [DOI] [Google Scholar]
- 17.Fu C, Zhao Q, Li Z, et al. Complete genome sequence of Halomonas ventosae virulent halovirus QHHSV-1. Arch Virol. 2017;162:3215–3219. doi: 10.1007/s00705-017-3415-0. [DOI] [PubMed] [Google Scholar]
- 18.Rodela ML, Sabet S, Peterson A, et al. Broad environmental tolerance for a salicola host-phage pair isolated from the cargill solar saltworks, Newark, CA, USA. Microorganisms. 2019;7:106–122. doi: 10.3390/microorganisms7040106. [DOI] [PMC free article] [PubMed] [Google Scholar]
- 19.Yoon SH, Ha SM, Kwon S, et al. Introducing EzBioCloud: a taxonomically united database of 16S rRNA gene sequences and whole-genome assemblies. Int J Syst Evol Microbiol. 2017;67:1613–1617. doi: 10.1099/ijsem.0.001755. [DOI] [PMC free article] [PubMed] [Google Scholar]
- 20.Tiiu K, Hans-W A, Usha G, et al. A bacteriophage of a moderately halophilic bacterium. Arch Microbiol. 1991;156:435–438. doi: 10.1007/BF00245388. [DOI] [Google Scholar]
- 21.Usha G, Tiiu K, Donn JK, et al. A moderately halophilic Vibrio from a Spanish saltern and its lytic bacteriophage. Can J Microbiol. 1996;42:1015–1023. doi: 10.1139/m96-130. [DOI] [Google Scholar]
- 22.Khayat R, Tang L, Larson ET, et al. Structure of an archaeal virus capsid protein reveals a common ancestry to eukaryotic and bacterial viruses. PNAS. 2005;102:18944–18949. doi: 10.1073/pnas.0506383102. [DOI] [PMC free article] [PubMed] [Google Scholar]
- 23.Fu CQ, Zhao Q, Li ZY, et al. A novel Halomonas ventosae-specific virulent halovirus isolated from the Qiaohou salt mine in Yunnan, Southwest China. Extremophiles. 2016;20:101–110. doi: 10.1007/s00792-015-0802-x. [DOI] [PubMed] [Google Scholar]
- 24.Nuttall SD, Dyall-Smith ML. HF1 and HF2: novel bacteriophages of halophilic archaea. Virology. 1993;197:678–684. doi: 10.1006/viro.1993.1643. [DOI] [PubMed] [Google Scholar]
- 25.Hanna MK, Elina R, Petra K, et al. Quantitative dissociation of archaeal virus SH1 reveals distinct capsid proteins and a lipid core. Virology. 2006;356:4–11. doi: 10.1016/j.virol.2006.07.027. [DOI] [PubMed] [Google Scholar]
- 26.Wang CX, Li X. JMT-1: a novel, spherical lytic halotolerant phage isolated from Yuncheng saline lake. Braz J Microbiol. 2018;49:262–268. doi: 10.1016/j.bjm.2018.03.004. [DOI] [PMC free article] [PubMed] [Google Scholar]
- 27.Suttle CA, Fuhrman JA. Enumeration of virus particles in aquatic or sediment samples by epifluorescence microscopy. MAVE. 2010;15:145–153. doi: 10.4319/mave.2010.978-0-9845591-0-7.145. [DOI] [Google Scholar]
- 28.Porter K, Tang SL, Chen CP, et al. PH1: an archaeovirus of Haloarcula hispanica related to SH1 and HHIV-2. Archaea. 2013;2013:456318. doi: 10.1155/2013/456318. [DOI] [PMC free article] [PubMed] [Google Scholar]
- 29.Kukkaro P, Bamford DH. Virus-host interactions in environments with a wide range of ionic strengths. Environ Microbiol Rep. 2009;1:71–77. doi: 10.1111/j.1758-2229.2008.00007.x. [DOI] [PubMed] [Google Scholar]
- 30.Yu HY, Cao JB, Li X. Isolation and characterization of a bacteriophage CJL-1 infecting halophilic bacteria. Biotechnology. 2015;25:56–60. doi: 10.16519/j.cnki.1004-311x.2015.01.011. [DOI] [Google Scholar]
- 31.Nikita Z, Elina C, Andris D, et al. Isolation and characterization of the novel Virgibacillus-infecting bacteriophage Mimir87. Arch Virol. 2020;165:737–741. doi: 10.1007/s00705-019-04516-2. [DOI] [PubMed] [Google Scholar]